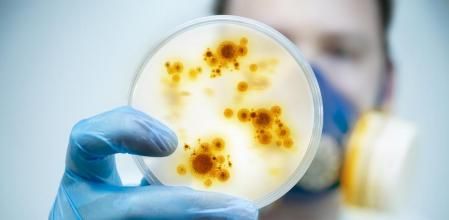
Horizontal

Los nuevos antibióticos que a día de hoy se están investigando son insuficientes para hacer frente a la creciente amenaza de las bacterias resistentes, según un informe que publica hoy la Organización Mundial de la Salud (OMS). La institución reclama más financiación para investigar la resistencia a los antibióticos, y pide una mayor implicación de la industria farmacéutica.
El pasado febrero, la OMS publicó una lista de las bacterias consideradas de mayor riesgo para la salud humana por haberse vuelto resistentes a los antibióticos. Entre ellas, la más peligrosa es la que causa la tuberculosis, Mycobacterium tuberculosis, y la siguen de cerca otros patógenos que provocan infecciones hospitalarias, como neumonías, infecciones de orina y de la sangre o meningitis. Frente a estos microorganismos, muchas de las armas antibacterianas desarrolladas en las últimas décadas son totalmente inútiles. Se han detectado incluso casos de infecciones –de gonorrea– que resisten absolutamente todos los antibióticos.
Si no aumenta la financiación en investigación, regresaremos a un tiempo en el que las personas temían las infecciones comunes y arriesgaban sus vidas en cirugías menores”
Ahora, la OMS ha analizado qué fármacos se están ensayando actualmente contra los patógenos más prioritarios, y ha concluido que faltan antibióticos para combatir las infecciones resistentes.
Los expertos calculan que de los 62 fármacos que están en fase de ensayo clínico en estos momentos, en cinco años se habrán aprobado unos diez –muchos de ellos no llegan a superar las pruebas necesarias para ser aprobados. Esta cifra “no es suficiente para enfrentar la inminente amenaza de la resistencia a fármacos antimicrobianos”, advierte el informe de la OMS.

La tuberculosis y algunas infecciones hospitalarias son las principales amenazas bacterianas para la salud humana. Muchas de las cepas ya son resistentes a múltiples antibióticos
La OMS también señala que la mayoría de antibióticos en investigación son variaciones de otros que ya existen, por lo que son sólo una solución a corto plazo, ya que las bacterias pueden desarrollar resistencia en poco tiempo. Por otra parte, el análisis de la OMS destaca que el peso de la inversión en investigación sobre antibióticos recae en su mayor parte en instituciones públicas y fundaciones filantrópicas, como la Wellcome Trust del Reino Unido. En cambio, el papel de la industria farmacéutica es mucho menor, a diferencia de lo que ocurre con otros tipos de enfermedades, por lo que la OMS reclama a este sector que aumente su implicación en la búsqueda de nuevos antibióticos.
“Tenemos una gran necesidad de aumentar la inversión en investigación sobre infecciones resistentes a antibióticos, incluida la tuberculosis. Si no, regresaremos a un tiempo en el que las personas temían las infecciones comunes y arriesgaban sus vidas en cirugías menores”, declara Tedros Adhanom Ghebreyesus, Director General de la OMS, en un comunicado difundido por la organización.
Algunas infecciones resisten ya a absolutamente todos los antibióticos, lo que las hace intratables
Según una revisión publicada en 2016, y encargada por el entonces Primer Ministro del Reino Unido, David Cameron, si la situación sigue como hasta ahora, a partir de 2050 cada año morirán 10 millones de personas por la resistencia a antibióticos. Como referencia, actualmente mueren algo más de 8 millones de personas por cáncer cada año.
Una búsqueda cada vez más difícil
Gran parte de los antibióticos usados hoy en día se descubrieron en los años cincuenta y sesenta del siglo pasado, en una época dorada para la guerra antibacteriana. Gracias a ellos, la mortalidad por infecciones disminuyó drásticamente. Pero su uso indebido ha propiciado que cada vez más bacterias se hayan vuelto resistentes, hasta el punto de que algunas cepas son inmunes a tantos antibióticos que ya no hay forma de tratarlas.
“Antes, las empresas farmacéuticas enviaban expediciones a lugares remotos de la Tierra, en busca de hongos y bacterias que produjeran sustancias antibacterianas. Pero ahora eso se está acabando”, explica Jordi Vila, jefe del servicio de microbiología del Hospital Clínic de Barcelona. Y director de la Inicitiva de Resistencia Antimicrobana en el Insituto de Salud Global de Barcelona . “Ahora se buscan nuevos ecosistemas, como los fondos marinos, pero el problema es que muchos de los antibióticos que se encuentran ya se habían descubierto”, declara en entrevista telefónica Jordi Vila, que también es vicepresidente de la Sociedad Española de Enfermedades Infecciosas y Microbiología Clínica (SEIMC).
Según Vila, hay otras formas de desarrollar nuevos fármacos. Por ejemplo, sintetizarlos desde cero en el laboratorio, o bien buscar estrategias totalmente nuevas. “No obstante, para eso hay que invertir un gran esfuerzo, ya que científicamente es un reto mucho mayor. Por eso, hace falta más inversión, y más implicación de la industria farmacéutica”, remarca Jordi Vila.
Prevenir antes que curar
La OMS subraya que los esfuerzos en encontrar nuevos antibióticos no serán suficientes por sí solos. A la vez, será necesario reforzar la prevención, para frenar el ritmo de aparición y propagación de nuevas resistencias. Según Jordi Vila, hay medidas que podemos tomar todos:
Seguir las recomendaciones de los médicos. Dejar un tratamiento con antibióticos antes de tiempo o automedicarse favorece que las bacterias desarrollen resistencia. Además, la mayoría de las infecciones a las que nos enfrentamos las provocan virus, contra los que los antibióticos no sirven de nada.
Higiene alimentaria. Lavar bien los alimentos que consumamos crudos o cocinarlos a altas temperaturas evita infecciones.
Lavarse bien las manos. Especialmente después de ir por la calle o en transporte público.